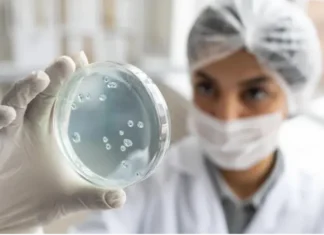

SP investiga biomarcadores para a detecção precoce da doença de Alzheimer
Pesquisadores da Universidade Federal de São Carlos (UFSCar) estão desenvolvendo um painel de biomarcadores para a detecção precoce da doença de Alzheimer e para...
SP apoia novo centro que vai estudar micoses endêmicas na América Latina
Apesar de uma incidência anual de 6,5 milhões de infecções fúngicas invasivas no mundo, com 3,8 milhões de mortes, segundo levantamento recente, as micoses são subnotificadas...
SP apoia vacina terapêutica para doenças causadas por HPV
As doenças causadas pelo papilomavírus humano (HPV), como o câncer do colo uterino, podem ganhar um nova forma de tratamento por meio de uma...
Como a doação de sangue devolveu forças a um jovem em tratamento de câncer
Rafael Dias Rufino nunca se esquecerá do aniversário de 16 anos em 2023, quando, após os resultados de um exame de sangue, descobriu que...
Camuflar para ‘se encaixar’ traz consequências negativas para adultos com TEA, diz estudo
Para enfrentar as situações sociais do dia a dia, muitas pessoas autistas tentam ajustar seu comportamento para “se encaixar”. Às vezes, o ajuste passa...
Prefeitura aplica mais de 7 mil doses da vacina contra influenza em postos volantes...
Ação começou nesta segunda-feira (09) e segue até 27 de junho em terminais urbanos de ônibus, estações de Metrô e CPTM, entre outros locais;...
Vitamina D aumenta chance de câncer de mama desaparecer com quimioterapia, diz estudo
Estudo conduzido na Faculdade de Medicina de Botucatu da Universidade Estadual Paulista (FMB-Unesp) mostrou que a suplementação de vitamina D em baixa dosagem pode...
USP desenvolve sistema que remove resíduos de medicamentos da água potável
Pesquisadores comprovaram eficiência de nova forma de se remover contaminantes orgânicos de sistemas hídricos. Na Escola Politécnica (Poli) da USP, nanomateriais são manipulados para...
Butantan muda embalagens de soros antiveneno para facilitar a identificação dos produtos
O Instituto Butantan desenvolveu novas embalagens para seus soros, que agora apresentam uma cor para cada produto e ilustrações dos animais, da toxina ou...
Meses frios pedem cuidados os olhos; veja dicas
No período mais frio do ano, algumas doenças relacionadas aos olhos, principalmente à superfície ocular, são mais frequentes. Eduardo Rocha, oftalmologista, professor da USP...